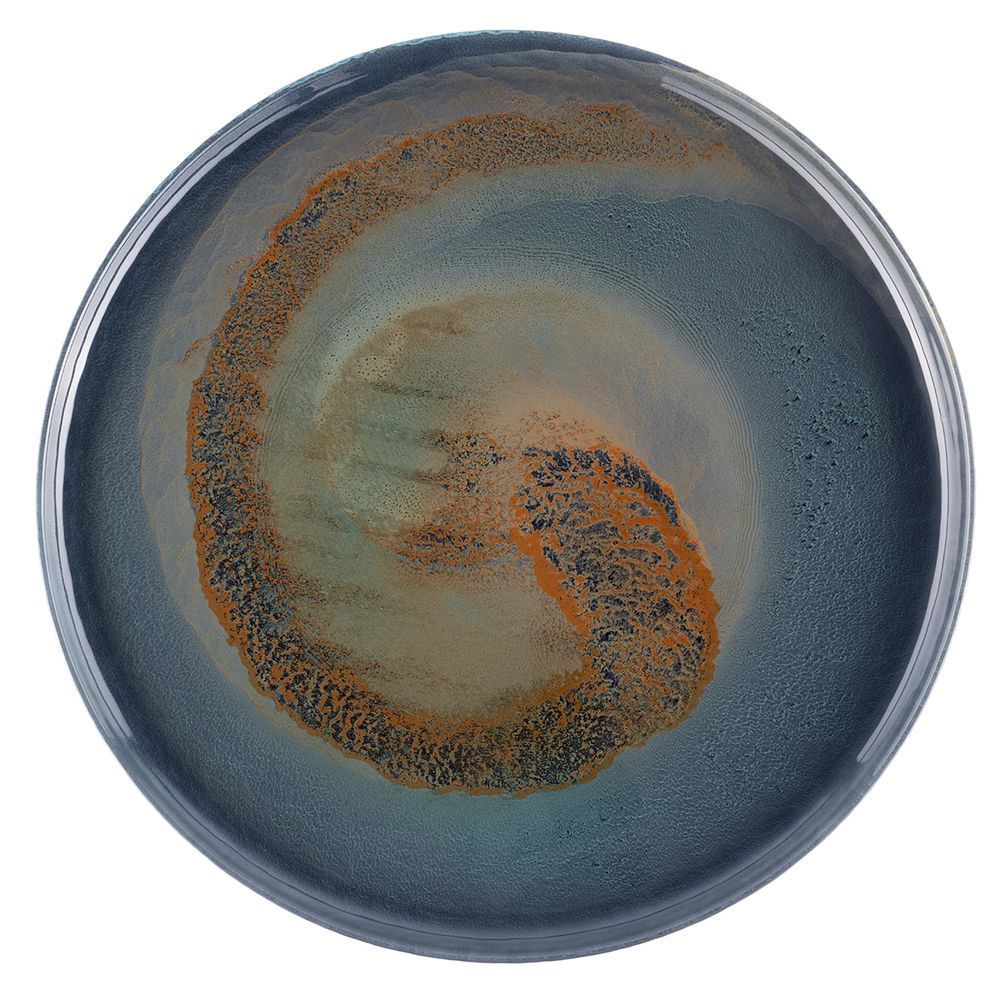
Тарелка сервировочная Gipfel Vortex 43212 33 см

Характеристики
Бренд
Коллекция/Серия
Материал
Стекло
Высота, см
2
Диаметр, см
33
Краткое описание
Тарелка сервировочная Gipfel Vortex 43212 33 см. Изготовлена из стекла ручной работы. Тарелка с глянцевой поверхностью с разноцветной сине-зеленой палитрой.
Цвет
Синий, Зеленый
Коллекция
Vortex
Вес, кг
1.006
Количество элементов
1
Мытье в посудомоечной машине
Нет
Размер, см
33x2
Описание
Тарелка сервировочная Gipfel Vortex 43212 33 см. Изготовлена из стекла.
Посуда из стекла практичная, не впитывает запахи и влагу, легко отмывается от загрязнений. Стеклянная посуда ручной работы украшает интерьер и придает ему особую легкость и изящество. Каждое изделие, сделанное вручную, обладает неповторимостью и уникальностью.
Тарелка выполнена с глянцевой поверхностью в удивительной палитре цветов: от изумрудно-зеленого, переходящего в янтарный, медовый и коричневые оттенки, дополненных акцентами синего, от нежно-голубых до индиго.
Это декоративный элемент для изысканной сервировки стола.
Сервировочную тарелку используют как красивую подставку под другую посуду: под салатные тарелки, креманки, для использованных приборов и т.д.
Тарелки серии Vortex представлены в разных размерах, из них вы можете собрать целый набор в едином стиле.
Рекомендации по использованию и уходу:
Рекомендуется избегать резкого нагрева материала и его чрезмерного охлаждения, так как стекло очень чувствительно к перепадам температуры.
Беречь от ударов и падений.
Не рекомендуется мыть в посудомоечной машине.
Не рекомендуется использовать в микроволновой печи.
Не использовать абразивные средства или металлические мочалки.
Для мытья использовать жидкие моющие средства и мягкую губку.
Показать полностью
Отзывы
Отзывов еще никто не оставлял
Описание
Тарелка сервировочная Gipfel Vortex 43212 33 см. Изготовлена из стекла.
Посуда из стекла практичная, не впитывает запахи и влагу, легко отмывается от загрязнений. Стеклянная посуда ручной работы украшает интерьер и придает ему особую легкость и изящество. Каждое изделие, сделанное вручную, обладает неповторимостью и уникальностью.
Тарелка выполнена с глянцевой поверхностью в удивительной палитре цветов: от изумрудно-зеленого, переходящего в янтарный, медовый и коричневые оттенки, дополненных акцентами синего, от нежно-голубых до индиго.
Это декоративный элемент для изысканной сервировки стола.
Сервировочную тарелку используют как красивую подставку под другую посуду: под салатные тарелки, креманки, для использованных приборов и т.д.
Тарелки серии Vortex представлены в разных размерах, из них вы можете собрать целый набор в едином стиле.
Рекомендации по использованию и уходу:
Рекомендуется избегать резкого нагрева материала и его чрезмерного охлаждения, так как стекло очень чувствительно к перепадам температуры.
Беречь от ударов и падений.
Не рекомендуется мыть в посудомоечной машине.
Не рекомендуется использовать в микроволновой печи.
Не использовать абразивные средства или металлические мочалки.
Для мытья использовать жидкие моющие средства и мягкую губку.
Характеристики
Бренд
GIPFEL
Коллекция/Серия
GIPFEL Vortex
Материал
Стекло
Высота, см
2
Диаметр, см
33
Краткое описание
Тарелка сервировочная Gipfel Vortex 43212 33 см. Изготовлена из стекла ручной работы. Тарелка с глянцевой поверхностью с разноцветной сине-зеленой палитрой.
Цвет
Синий, Зеленый
Коллекция
Vortex
Вес, кг
1.006
Количество элементов
1
Мытье в посудомоечной машине
Нет
Размер, см
33x2